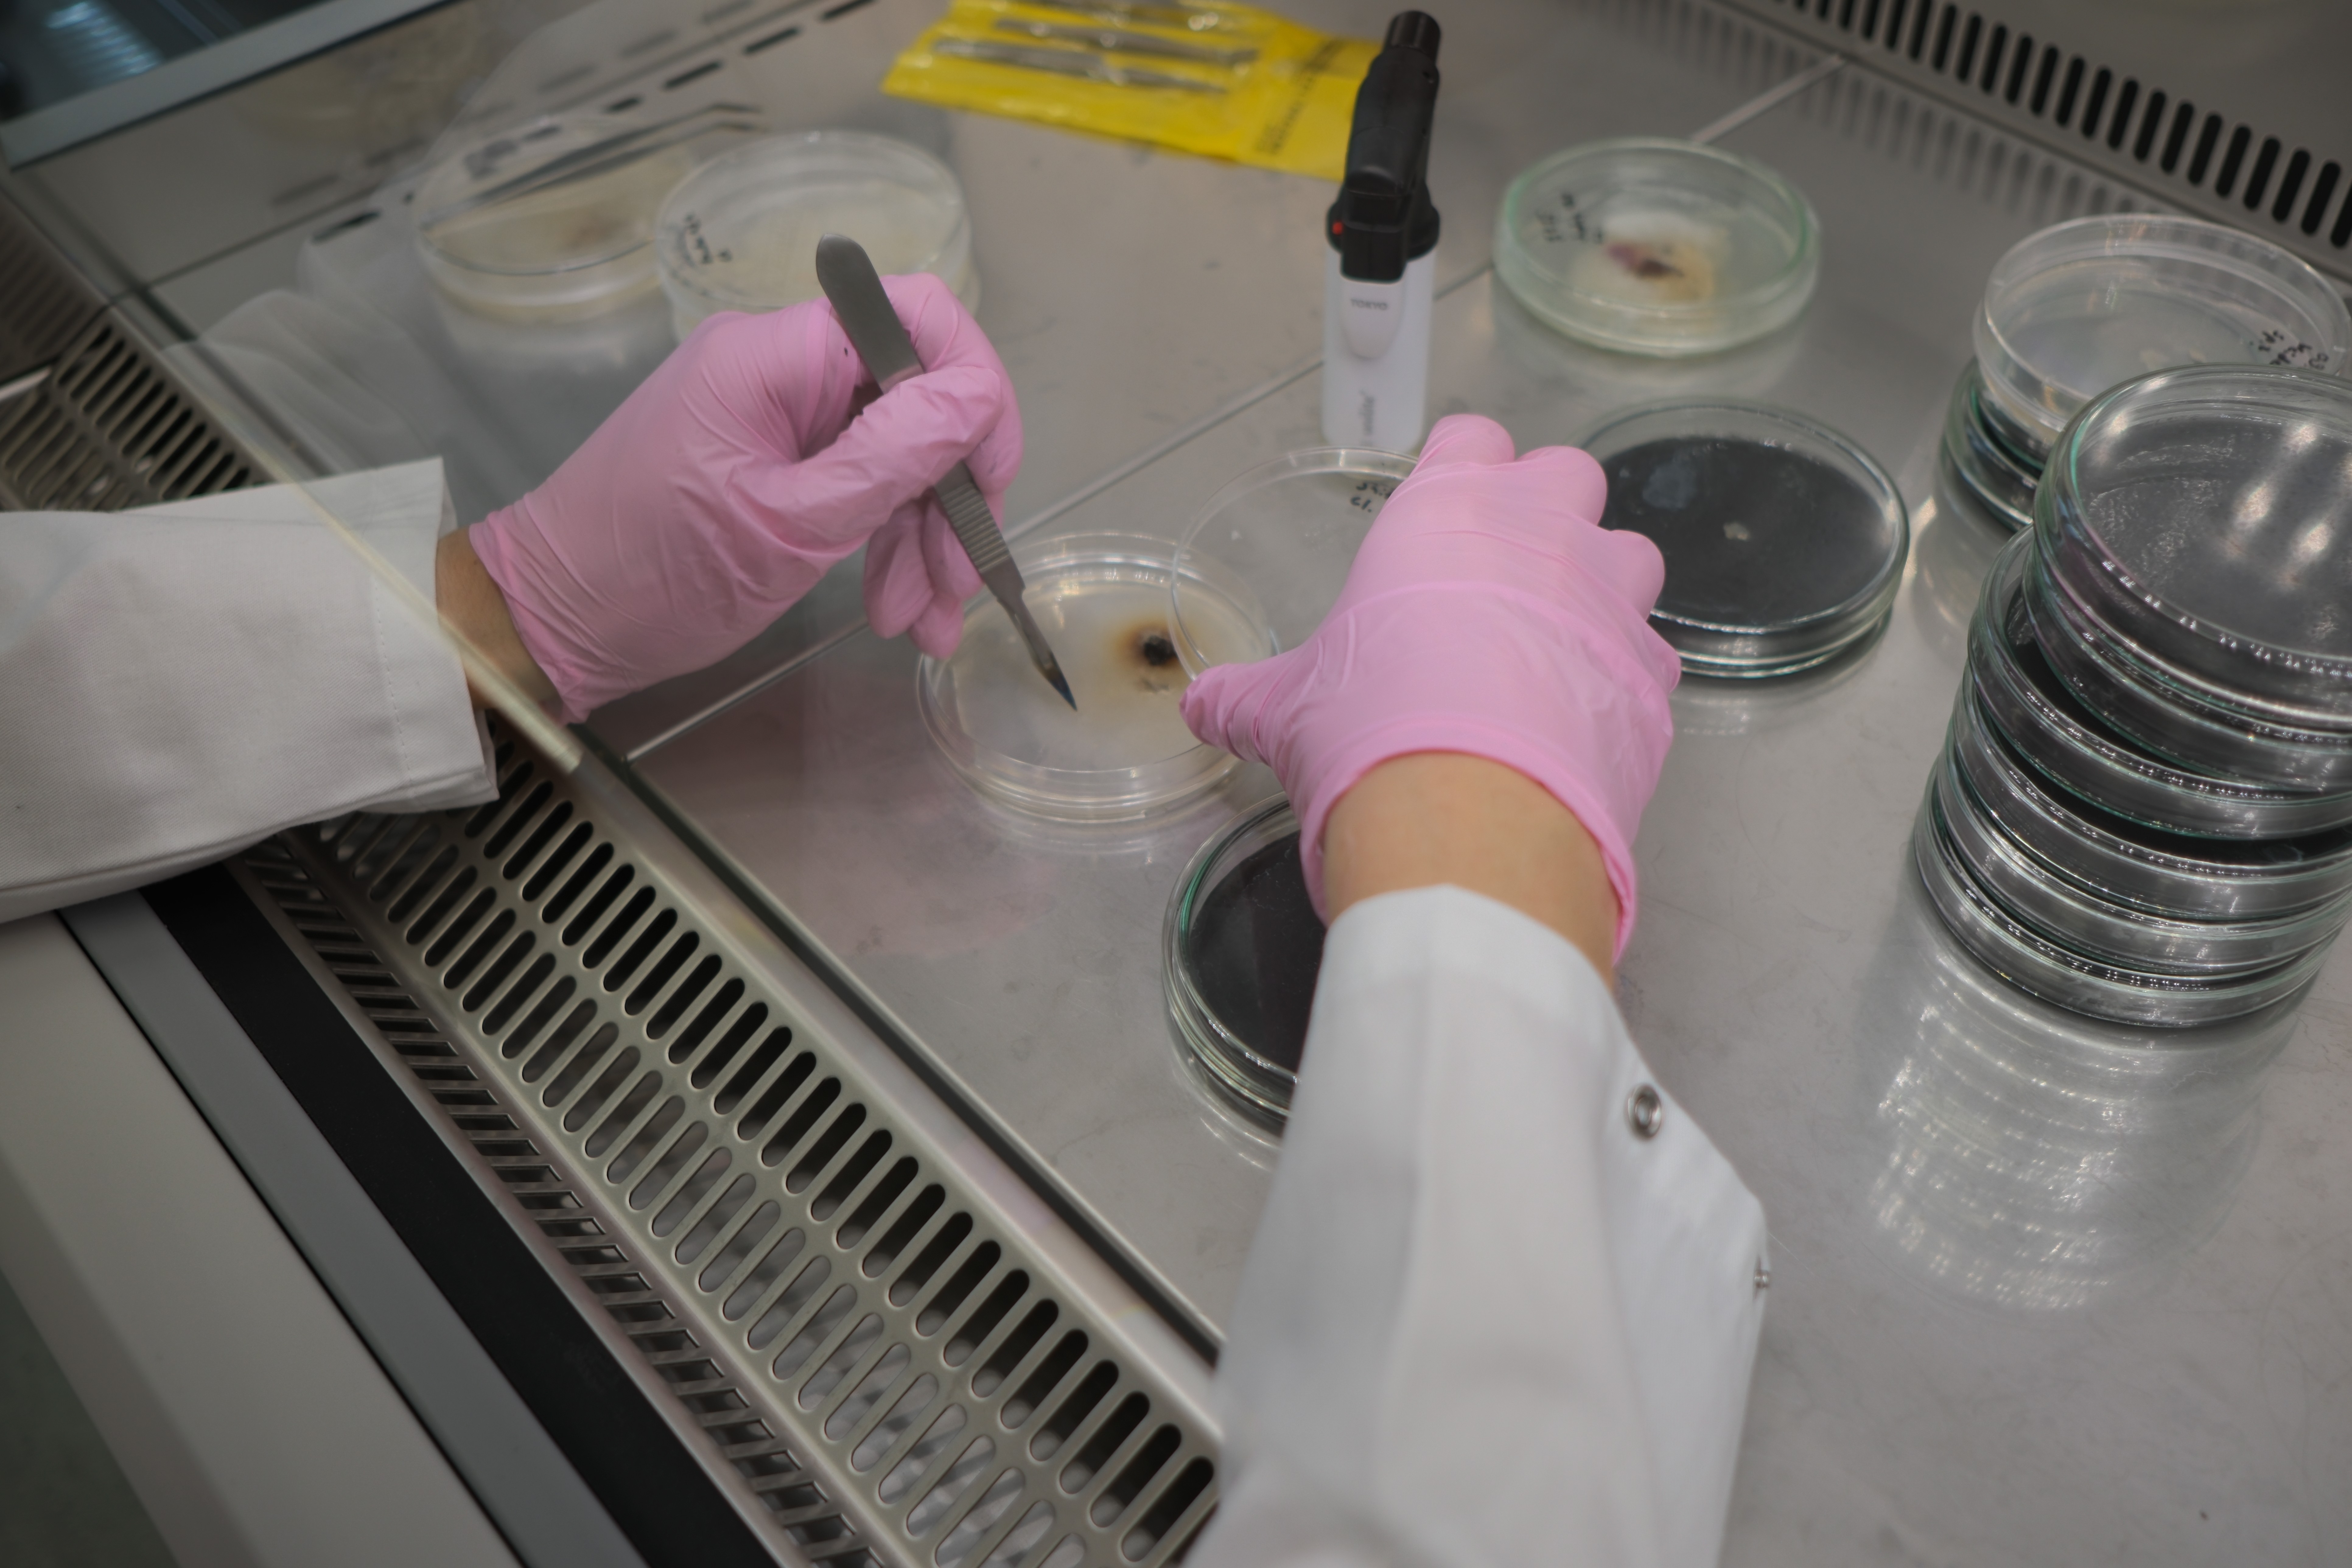

Diese Plattform wird von Studierenden und Mitarbeitenden der ZHdK betrieben, die sich mit Materialien, Prozessen und deren gestalterischem Potenzial auseinandersetzen. Sie dient als zentraler Ort, um Projekte sichtbar zu machen, Wissen zugänglich zu halten und laufende Experimente zu dokumentieren.
Ziel ist es, Ergebnisse aus Lehre und Praxis strukturiert zu sammeln, den Austausch zwischen Disziplinen zu erleichtern und die Entwicklung neuer materialbasierter Ansätze zu unterstützen. Die Plattform wächst mit jedem Projekt weiter und bildet eine offene, kontinuierlich ergänzte Übersicht über das materialorientierte Arbeiten an der ZHdK.
Biolab
Das BioLab ist ein offener Arbeitsraum für Experimente mit lebenden und biobasierten Materialien. Hier entstehen Projekte, die sich mit Wachstum, Transformation und alternativen Werkstoffen beschäftigen. Das Labor bietet eine kontrollierte Umgebung für sichere Versuche, unterstützt Forschung im kleinen Massstab und ermöglicht es Studierenden, praxisnah mit biologischen Prozessen zu arbeiten.
OutLab
Das OutLab erweitert diese Arbeit nach draussen. Es ist ein Testfeld für Materialexperimente unter realen Umweltbedingungen – Sonne, Regen, Temperaturwechsel und Zeit. Hier werden Prototypen ausgestellt, Alterungsprozesse beobachtet und Ergebnisse direkt im Kontext ihrer späteren Anwendung geprüft. Das OutLab fungiert als Brücke zwischen Labor und öffentlichem Raum und macht Experimente sichtbar, die sonst verborgen blieben.